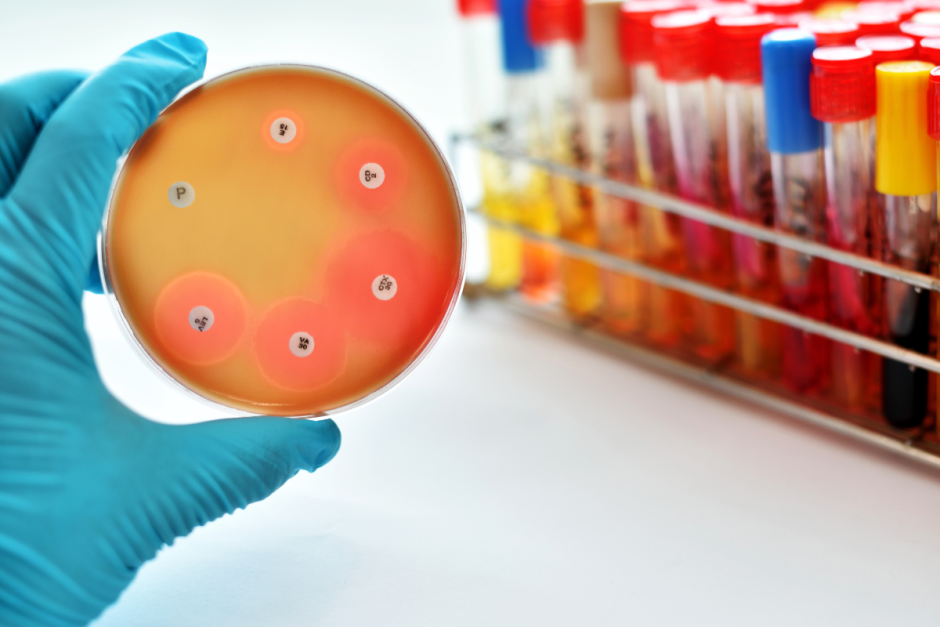
лекарство.png

Он лучше пенициллина и помогает не только человеку, но и растениям. 22 февраля 1946 года американский микробиолог Зельман Ваксман открыл антибиотик стрептомицин (некоторые источники называют датой открытия 19 октября).
Стрептомицин — второй, после пенициллина открытый антибиотик, но первый, оказавшийся эффективным против туберкулёза и чумы.
За свое открытие в 1952 году доктор получил Нобелевскую премию по физиологии и медицине.
Стрептомицин оказался более эффективным в отношении бактерий, устойчивых к пенициллину.
Не Ваксман?
Некоторые приписывают открытие стрептомицина 23-летнему аспиранту Ваксмана – Альберту Шацу. Молодой человек якобы сделал это под огромным влиянием доктора. В результате судебного разбирательства Шац получил 3% от гонораров и юридическое признание в качестве соавтора открытия.
Однако Нобелевская премия была присуждена исключительно Ваксману "за открытие стрептомицина".
Сегодня препарат расширил возможности хирургии при самых сложных формах туберкулеза почек, легких и др. В большинстве случаев достаточно 10 граммов стрептомицина, чтобы спасти пациента от смерти.
Лечит и деревья
Лекарство также используется в качестве пестицида для борьбы с бактериями у растений. Препарат справляется с бактериальными заболеваниями фруктов, овощей, семян и декоративных культур. Основное применение в сельском хозяйстве — борьба с фитофторозом на яблонях и грушах.